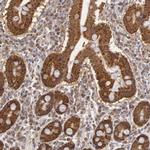
MPST Antibody in Immunohistochemistry (IHC)

Search
Invitrogen
MPST Polyclonal Antibody
{{$productOrderCtrl.translations['antibody.pdp.commerceCard.promotion.promotions']}}
{{$productOrderCtrl.translations['antibody.pdp.commerceCard.promotion.viewpromo']}}
{{$productOrderCtrl.translations['antibody.pdp.commerceCard.promotion.promocode']}}: {{promo.promoCode}} {{promo.promoTitle}} {{promo.promoDescription}}. {{$productOrderCtrl.translations['antibody.pdp.commerceCard.promotion.learnmore']}}
产品信息
PA5-51548
种属反应
已发表种属
宿主/亚型
分类
类型
抗原
偶联物
形式
浓度
规格
纯化类型
保存液
内含物
保存条件
运输条件
RRID
产品详细信息
Immunogen sequence: AVSLLDGGLR HWLRQNLPLS SGKSQPAPAE FRAQLDPAFI KTYEDIKENL ESRRFQVVDS RATGRFRGTE PEPRDGIEPG HIPGTVNIPF TDFLSQEGLE KSPEEIRHLF QEKKVDLSKP LVATCGSGVT ACHVALGAYL CGKPD
Highest antigen sequence identity to the following orthologs: Mouse - 81%, Rat - 82%.
靶标信息
This protein encoded by this gene catalyzes the transfer of a sulfur ion from 3-mercaptopyruvate to cyanide or other thiol compounds. It may be involved in cysteine degradation and cyanide detoxification. There is confusion in literature between this protein (mercaptopyruvate sulfurtransferase, MPST), which appears to be cytoplasmic, and thiosulfate sulfurtransferase (rhodanese, TST, GeneID:7263), which is a mitochondrial protein. Deficiency in MPST activity has been implicated in a rare inheritable disorder known as mercaptolactate-cysteine disulfiduria (MCDU). Alternatively spliced transcript variants encoding same or different isoforms have been identified for this gene.
仅用于科研。不用于诊断过程。未经明确授权不得转售。
生物信息学
蛋白别名: 3-mercaptopyruvate sulfurtransferase; human liver rhodanese; MPST; MST; testicular tissue protein Li 200; tRNA thiouridin modification protein 1; unnamed protein product
基因别名: MPST; MST; TST2; TUM1
UniProt ID: (Human) P25325
Entrez Gene ID: (Human) 4357